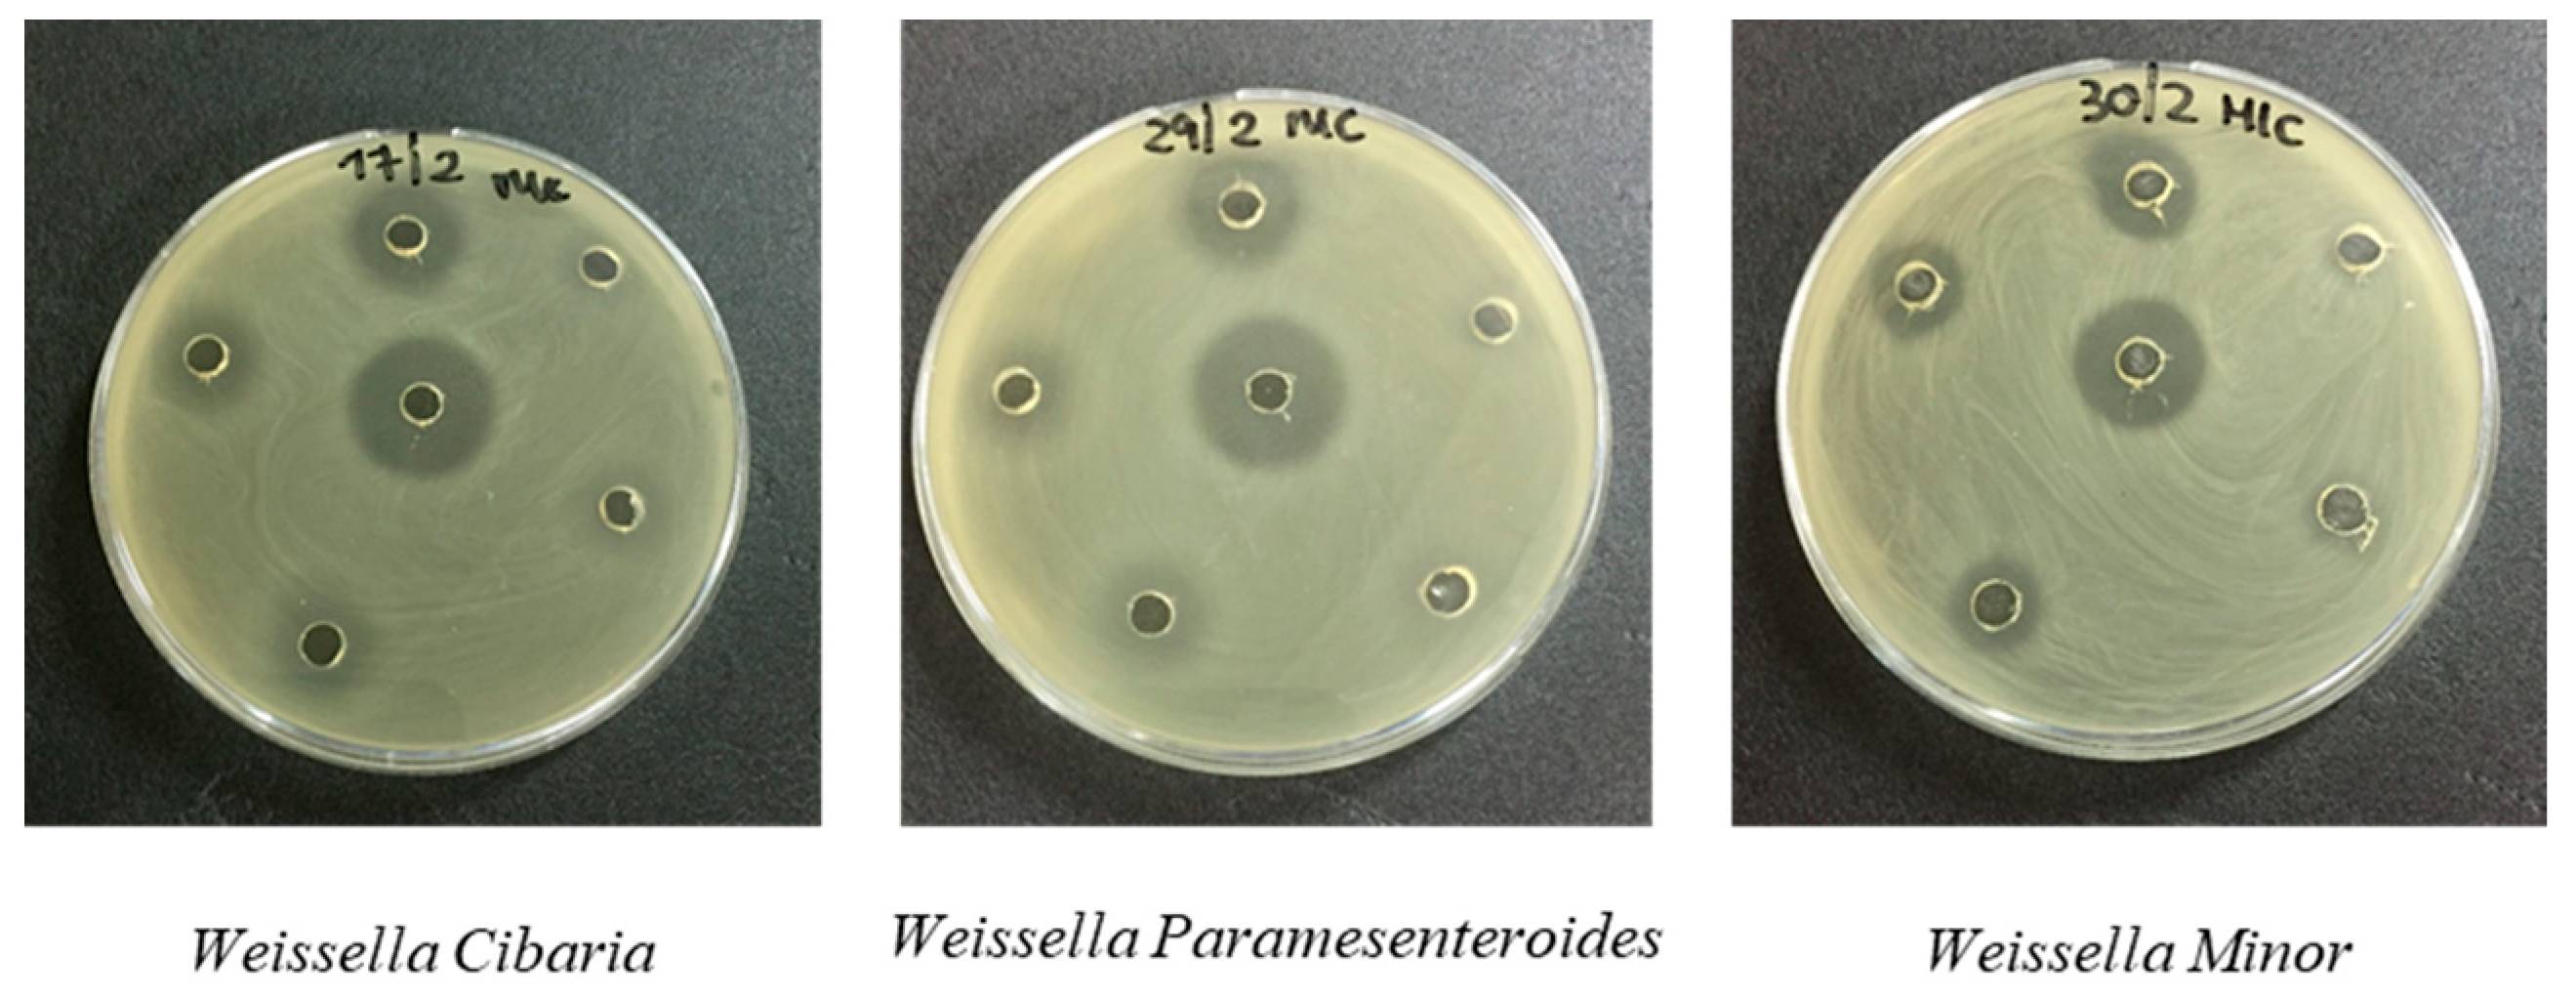
Antibiotics 10 01466 g001

Bis-Thiourea Quaternary Ammonium Salts as Potential Agents against Bacterial Strains from Food and Environmental Matrices
Abstract
:1. Introduction
2. Materials and Methods
2.1. Thiourea Derivatives
2.2. Chemistry
Synthesis of Pentane-1,5-diyl-bis-S-Amidinothiourea Dihydrobromide (4)
2.3. Bacterial Strains and Growth Conditions
2.4. Agar Well Diffusion Assay and Minimum Inhibitory Concentration (MIC)
3. Results and Discussion
3.1. Chemistry
3.2. Antimicrobial In Vitro Evaluation
4. Conclusions
Author Contributions
Funding
Data Availability Statement
Conflicts of Interest
Abbreviations
References
- Ferri, M.; Ranucci, E.; Romagnoli, P.; Giaccone, V. Antimicrobial resistance: A global emerging threat to public health systems. Crit. Rev. Food Sci. Nutr. 2017, 57, 2857–2876. [Google Scholar] [CrossRef]
- De Rosa, M.; Bonomo, M.G.; Vassallo, A.; Palma, G.; Calabrone, L.; Bimonte, S.; Silvestris, N.; Amruthraj, N.J.; Sinicropi, M.S.; Salzano, G.; et al. Linezolid and its derivatives: The promising therapeutic challenge to multidrug-resistant pathogens. Pharmacologyonline 2018, 2, 134–148. [Google Scholar]
- Bonomo, M.G.; Calabrone, L.; Saturnino, C.; Sinicropi, M.S.; Capasso, A.; Salzano, G. Antibacterial activity of new β-lactam compound. PharmacologyOnLine 2019, 3, 185–194. [Google Scholar]
- De Kraker, M.E.A.; Stewardson, A.J.; Harbarth, S. Will 10 million people die a year due to antimicrobial resistance by 2050? PLoS Med. 2016, 13, e1002184. [Google Scholar] [CrossRef] [PubMed] [Green Version]
- Barchitta, M.; Quattrocchi, A.; Maugeri, A.; La Rosa, M.C.; La Mastra, C.; Sessa, L.; Cananzi, P.; Murolo, G.; Oteri, A.; Basile, G.; et al. Antibiotic consumption and resistance during a 3-year period in Sicily, Southern Italy. Int. J. Environ. Res. Public Health 2019, 16, 2253. [Google Scholar] [CrossRef] [Green Version]
- Pantaleo, E.; Gamalero, E.; Leli, C.; Rocchetti, A. Il sistema di sorveglianza dell’antibiotico resistenza AR-ISS: Uno strumento efficace per migliorare la gestione degli antibiotici. Work. Pap. Public Health 2021, 9, 1–29. [Google Scholar] [CrossRef]
- Santoro, A.; Cappello, A.R.; Madeo, M.; Martello, E.; Iacopetta, D.; Dolce, V. Interaction of fosfomycin with the glycerol 3-phosphate transporter of Escherichia coli. Biochim. Biophys. Acta 2011, 1810, 1323–1329. [Google Scholar] [CrossRef] [PubMed]
- Pozzi, C.; Ferrari, S.; Cortesi, D.; Luciani, R.; Stroud, R.M.; Catalano, A.; Costi, M.P.; Mangani, S. The structure of Enterococcus faecalis thymidylate synthase provides clues about folate bacterial metabolism. Acta Crystallogr. D Biol. Crystallogr. 2012, 68, 1232–1241. [Google Scholar] [CrossRef] [PubMed]
- Bonomo, M.G.; Salzano, G. Microbial diversity and dynamics of Pecorino di Filiano PDO, a traditional cheese of Basilicata region (Southern Italy). Int. J. Dairy Tech 2012, 65, 531–541. [Google Scholar] [CrossRef]
- Zhou, F.; Yu, T.; Du, R.; Fan, G.; Liu, Y.; Liu, Z.; Xiang, J.; Wang, Y.; Song, B.; Gu, X.; et al. Clinical course and risk factors for mortality of adult in patients with COVID-19 in Wuhan, China: A retrospective cohort study. Lancet 2020, 395, 1054–1062. [Google Scholar] [CrossRef]
- Caruso, A.; Ceramella, J.; Iacopetta, D.; Saturnino, C.; Mauro, M.V.; Bruno, R.; Aquaro, S.; Sinicropi, M.S. Carbazole derivatives as antiviral agents: An overview. Molecules 2019, 24, 1912. [Google Scholar] [CrossRef] [Green Version]
- Driggin, E.; Madhavan, M.V.; Bikdeli, B.; Chuich, T.; Laracy, J.; Bondi-Zoccai, G.; Brown, T.S.; Nigoghossian, C.D.; Zidar, D.A.; Haythe, J.; et al. Cardiovascular considerations for patients, health care workers, and health systems during the Coronavirus Disease 2019 (COVID-19) Pandemic. J. Am. Coll. Cardiol. 2020, 75, 2352–2371. [Google Scholar] [CrossRef]
- Giuzio, F.; Bonomo, M.G.; Armenante, G.; Barra, G.; Casolaro, G.; Di Ludovico, C.; Galasso, L.; Giacco, D.; Grassi, F.; Lardo, D. The monitoring model for covid-19 patients in the context of territorial medicine: The experience of the covid special unit (usco) of potenza. Pharmacologyonline 2021, 1, 214–223. [Google Scholar]
- Catalano, A. COVID-19: Could irisin become the handyman myokine of the 21st century? Coronaviruses 2020, 1, 32–41. [Google Scholar] [CrossRef]
- Catalano, A.; Iacopetta, D.; Pellegrino, M.; Aquaro, S.; Franchini, C.; Sinicropi, M. Diarylureas: Repositioning from antitumor to antimicrobials or multi-target agents against new pandemics. Antibiotics 2021, 10, 92. [Google Scholar] [CrossRef] [PubMed]
- Saturnino, C.; Grande, F.; Aquaro, S.; Caruso, A.; Iacopetta, D.; Bonomo, M.G.; Longo, P.; Schols, D.; Sinicropi, M.S. Chloro-1,4-dimethyl-9H-carbazole derivatives displaying anti-HIV activity. Molecules 2018, 23, 1–8. [Google Scholar] [CrossRef] [PubMed] [Green Version]
- Tabbi, A.; Tebbani, D.; Caporale, A.; Saturnino, C.; Nabavi, S.M.; Palma, G.; Arra, C.; Cantürk, Z.; Turan-Zitouni, G.; Merazig, H.; et al. New adamantyl chalcones: Synthesis, antimicrobial and anticancer activities. Curr Top. Med Chem 2017, 17, 498–506. [Google Scholar] [CrossRef]
- Bonomo, M.G.; Milella, L.; Martelli, G.; Salzano, G. Stress response assessment of Lactobacillus sakei strains selected as potential autochthonous starter cultures by flow cytometry and nucleic acid double staining analyses. J. Appl. Microbiol. 2013, 115, 786–795. [Google Scholar] [CrossRef] [PubMed]
- Langford, B.J.; So, M.; Raybardhan, S.; Leung, V.; Westwood, D.; MacFadden, D.R.; Soucy, J.R.; Daneman, N. Bacterial co-infection and secondary infection in patients with COVID-19: A living rapid review and meta-analysis. Clin. Microbiol. Infect. 2020, 26, 1622–1629. [Google Scholar] [CrossRef]
- Lagolio, E.; Valbonesi, S. L’antibiotico-resistenza al tempo del COVID-19: Tattiche e strategie. Med. Prat. 2020, 23–27. [Google Scholar]
- Chilamakuri, R.; Agarwal, S. COVID-19: Characteristics and Therapeutics. Cells 2021, 10, 206. [Google Scholar] [CrossRef]
- Hsu, J. How COVID-19 is accelerating the threat of antimicrobial resistance. BMJ 2020, 369, m1983. [Google Scholar] [CrossRef]
- Francomano, F.; Caruso, A.; Barbarossa, A.; Fazio, A.; La Torre, C.; Ceramella, J.; Mallamaci, R.; Saturnino, C.; Iacopetta, D.; Sinicropi, M.S. β-caryophyllene: A sesquiterpene with countless biological properties. Appl. Sci. 2019, 9, 5420. [Google Scholar] [CrossRef] [Green Version]
- Koziróg, A.; Kregiel, D.; Brycki, B. Action of monomeric/gemini surfactants on free cells and biofilm of Asaia lannensis. Molecules 2017, 22, 2036. [Google Scholar] [CrossRef] [PubMed] [Green Version]
- Sumitomo, T.; Maeda, T.; Nagamune, H.; Kourai, H. Bacterioclastic action of a bis-quaternary ammonium compound against Escherichia coli. Biocontrol Sci. 2004, 9, 1–9. [Google Scholar] [CrossRef] [Green Version]
- Rosato, A.; Catalano, A.; Carocci, A.; Carrieri, A.; Carone, A.; Caggiano, G.; Franchini, C.; Corbo, F.; Montagna, M.T. In vitro interactions between anidulafungin and nonsteroidal anti-inflammatory drugs on biofilms of Candida spp. Bioorg. Med. Chem. 2016, 24, 1002–1005. [Google Scholar] [CrossRef]
- Kwaśniewska, D.; Chen, Y.-L.; Wieczorek, D. Biological activity of quaternary ammonium salts and their derivatives. Pathogens 2020, 9, 459. [Google Scholar] [CrossRef] [PubMed]
- Hashem, H.E.; Amr, A.E.G.E.; Nossier, E.S.; Elsayed, E.A.; Azmy, E.M. Synthesis, antimicrobial activity and molecular docking of novel thiourea derivatives tagged with thiadiazole, imidazole and triazine moieties as potential DNA gyrase and topoisomerase IV inhibitors. Molecules 2020, 25, 2766. [Google Scholar] [CrossRef] [PubMed]
- De Rosa, M.; Zanfardino, A.; Notomista, E.; Wichelhaus, T.A.; Saturnino, C.; Varcamonti, M.; Soriente, A. Novel promising linezolid analogues: Rational design, synthesis and biological evaluation. Eur. J. Med. Chem. 2013, 69, 779–785. [Google Scholar] [CrossRef] [PubMed]
- Ceramella, J.; Mariconda, A.; Rosano, C.; Iacopetta, D.; Caruso, A.; Longo, P.; Sinicropi, M.S.; Saturnino, C. α–ω Alkenyl-bis-S-guanidine thiourea dihydrobromide affects HeLa cell growth hampering tubulin polymerization. ChemMedChem 2020, 15, 2306–2316. [Google Scholar] [CrossRef] [PubMed]
- Paesano, N.; Marzocco, S.; Vicidomini, C.; Saturnino, C.; Autore, G.; De Martino, G.; Sbardella, G. Synthesis and biological evaluation of 3-benzyl-1-methyl- and 1-methyl-3-phenyl-isothioureas as potential inhibitors of iNOS. Bioorg. Med. Chem. Lett. 2005, 15, 539–543. [Google Scholar] [CrossRef]
- Saturnino, C.; Buonerba, M.; Paesano, N.; Lancelot, J.C.; De Martino, G. In vitro anti-acanthamoeba action by thioureidic derivatives. Il Farm. 2003, 58, 819–822. [Google Scholar] [CrossRef]
- Pasero, C.; D’Agostino, I.; De Luca, F.; Zamperini, C.; Deodato, D.; Truglio, G.I.; Sannio, F.; Del Prete, R.; Ferraro, T.; Visaggio, D.; et al. Alkyl-guanidine compounds as potent broad-spectrum antibacterial agents: Chemical library extension and biological characterization. J. Med. Chem. 2018, 61, 9162–9176. [Google Scholar] [CrossRef] [PubMed]
- Zamperini, C.; Maccari, G.; Deodato, D.; Pasero, C.; D’Agostino, I.; Orofino, F.; De Luca, F.; Dreassi, E.; Docquier, J.D.; Botta, M. Identification, synthesis and biological activity of alkyl-guanidine oligomers as potent antibacterial agents. Scient. Rep. 2017, 7, 1–11. [Google Scholar] [CrossRef]
- Bonomo, M.G.; Cafaro, C.; Russo, D.; Faraone, I.; Milella, L.; Saturnino, C.; Capasso, A.; Sinicropi, M.S.; Salzano, G. Antimicrobial and antioxidant properties and phytochemical screening of different mother tinctures against food-borne bacteria. Pharmacologyonline 2020, 1, 150–161. [Google Scholar]
- Bonomo, M.G.; Cafaro, C.; Russo, D.; Calabrone, L.; Milella, L.; Saturnino, C.; Capasso, A.; Salzano, G. Antimicrobial activity, antioxidant properties and phytochemical screening of Aesculus hippocastanum mother tincture against food-borne bacteria. Lett. Drug Des. Discov. 2020, 16, 48–56. [Google Scholar] [CrossRef]
- CLSI. Methods for Dilution Antimicrobial Susceptibility Tests for Bacteria that Grow Aerobically, Approved [Document M7-A9]; Clinical and Laboratory Standards Institute: Wayne, PA, USA, 2012. [Google Scholar]
- Birnie, C.R.; Malamud, D.; Schnaare, R.L. Antimicrobial evaluation of N-alkyl betaines and N-alkyl-N, N-dimethylamine oxides with variations in chain length. Antimicrob. Agents Chemother. 2000, 44, 2514–2517. [Google Scholar] [CrossRef] [Green Version]

| Compound | Molecule Structure | Alkyl Chain(CH2)n |
|---|---|---|
| 1 | ![]() | n = 9 |
| 2 | ![]() | n = 5 |
| 3 | ![]() | n = 8 |
| 4 | ![]() | n = 5 |
| Label | Strain | Bacterial Species | Growth Conditions | |
|---|---|---|---|---|
| Temperature | Coltural Medium a | |||
| Gram-positive bacteria | ||||
| 1 | 9P | Carnobacterium maltaromaticum | 20 °C | TSYE Medium |
| 2 | H02 | Carnobacterium divergens | 20 °C | TSYE Medium |
| 3 | 7R1 | Brochothrix thermosphacta | 20 °C | TSYE Medium |
| 4 | LMG6399 | Enterococcus hirae | 37 °C | M17 Medium |
| 5 | ATCC14434 | Enterococcus faecium | 37 °C | M17 Medium |
| 6 | ATCC14433 | Enterococcus faecalis | 37 °C | M17 Medium |
| 7 | ATCC14436 | Enterococcus caseliflavus | 37 °C | M17 Medium |
| 8 | ATCC11576 | Enterococcus durans | 37 °C | M17 Medium |
| 9 | LMG13129 | Enterococcus gallinarum | 37 °C | M17 Medium |
| 10 | DSM 20410 | Weissella viridescens | 30 °C | MRS Medium |
| 11 | DSM 20196 | Weissella confusa | 30 °C | MRS Medium |
| 12 | DSM 7378 | Weissella hellenica | 30 °C | MRS Medium |
| 13 | DSM 15878 | Weissella cibaria | 30 °C | MRS Medium |
| 14 | DBPZ0062 | Lactobacillus sakei Ls1 | 30 °C | MRS Medium |
| 15 | DBPZ0098 | Lactobacillus sakei Ls2 | 30 °C | MRS Medium |
| 16 | DBPZ0224 | Staphylococcus xylosus | 30 °C | TSYE Medium |
| 17 | DBPZ0251 | Staphylococcus succinus | 30 °C | TSYE Medium |
| 18 | DBPZ0241 | Staphylococcus equorum | 30 °C | TSYE Medium |
| 19 | BL/26 | Listeria innocua | 30 °C | TSYE Medium |
| 20 | DSM20288 | Weissella paramesenteroides | 30 °C | MRS Medium |
| 21 | DSM20014 | Weissella minor | 30 °C | MRS Medium |
| 22 | DBPZ001 | Listeria monocytogenes | 30 °C | TSYE Medium |
| 23 | DSPZA11II | Lysinibacillus fusiformis | 30 °C | Plate count agar |
| 24 | DSPZA12TII | Bacillus subtilis | 30 °C | Plate count agar |
| 25 | DSPZA2TI | Planococcus psychrotoleratus | 30 °C | Plate count agar |
| 26 | DSPZA5TI | Bacillus amyloliquefaciens | 30 °C | Plate count agar |
| 27 | DSPZA8TII | Bacillus anthracis | 30 °C | Plate count agar |
| 28 | DSPZA102II | Bacillus amyloliquefaciens | 30 °C | Plate count agar |
| 29 | DSPZA4I | Bacillus cereus Bc1 | 30 °C | Plate count agar |
| 30 | DSPZA191I | Bacillus cereus Bc2 | 30 °C | Plate count agar |
| Gram-negative bacteria | ||||
| 31 | 6P2 | Pseudomonas fragi | 20 °C | TSYE Medium |
| 32 | 53M | Hafnia alvei | 30 °C | TSYE Medium |
| 33 | 42M | Pseudomonas proteamaculans | 30 °C | TSYE Medium |
| 34 | 32 | Escherichia coli | 37 °C | TSYE Medium |
| 35 | DBPZ002 | Salmonella serovar | 30 °C | TSYE Medium |
| 36 | DSPZA141II | Pseudomonas orientalis | 30 °C | Plate count agar |
| Compound 1 | Compound 2 | Compound 3 | Compound 4 | ||||||
|---|---|---|---|---|---|---|---|---|---|
| Label | Bacterial Strains | Inhibition Zone a | MIC (mg/mL) | Inhibition Zone a | MIC (mg/mL) | Inhibition Zone a | MIC (mg/mL) | Inhibition Zone a | MIC (mg/mL) |
| Gram-positive bacteria | |||||||||
| 1 | Carnobacterium maltaromaticum | 1.1 ± 0.21 | 50 ± 0.67 | / | / | / | / | / | / |
| 2 | Carnobacterium divergens | / | / | / | / | / | / | / | / |
| 3 | Brochothrix thermosphacta | / | / | / | / | / | / | / | / |
| 4 | Enterococcus hirae | 1.5 ± 0.34 | 25 ± 0.81 | / | / | / | / | 1.3 ± 0.76 | 25 ± 0.69 |
| 5 | Enterococcus faecium | 1.5 ± 0.11 | 50 ± 0.99 | / | / | / | / | 1.4 ± 0.48 | 50 ± 0.36 |
| 6 | Enterococcus faecalis | 1.6 ± 0.07 | 25 ± 0.21 | / | / | / | / | 1.5 ± 0.05 | 50 ± 0.08 |
| 7 | Enterococcus casseliflavus | 2.0 ± 0.08 | 12.5 ± 0.66 | / | / | / | / | 1.9 ± 0.08 | 12.5 ± 0.22 |
| 8 | Enterococcus durans | 2.0 ± 0.11 | 50 ± 0.88 | / | / | / | / | 1.7 ± 0.77 | 50 ± 0.88 |
| 9 | Enterococcus gallinarum | 1.5 ± 0.03 | 25 ± 0.79 | / | / | / | / | 2.0 ± 0.34 | 12.5 ± 0.90 |
| 10 | Weissella viridescens | / | / | 1.2 ± 0.08 | 50 ± 0.90 | / | / | / | / |
| 11 | Weissella confusa | 2.0 ± 0.65 | 6.25 ± 0.78 | 1.4 ± 0.15 | 50 ± 0.22 | / | / | 1.6 ± 0.66 | 50 ± 0.05 |
| 12 | Weissella hellenica | 1.4 ± 0.37 | 25 ± 0.67 | / | / | / | / | 1.2 ± 0.80 | 25 ± 0.78 |
| 13 | Weissella cibaria | 2.0 ± 0.12 | 12.5 ± 0.79 | / | / | / | / | 1.5 ± 0.37 | 50 ± 0.88 |
| 14 | Lactobacillus sakei Ls1 | 1.4 ± 0.69 | 12.5 ± 0.62 | / | / | / | / | 1.6 ± 0.79 | 12.5 ± 0.99 |
| 15 | Lactobacillus sakei Ls2 | 1.6 ± 0.67 | 12.5 ± 0.04 | / | / | / | / | 1.5 ± 0.04 | 12.5 ± 0.08 |
| 16 | Staphylococcus xylosus | 1.5 ± 0.70 | 50 ± 0.09 | / | / | / | / | 1.7 ± 0.72 | 50 ± 0.36 |
| 17 | Staphylococcus succinus | 1.7 ± 0.11 | 50 ± 0.55 | 1.2 ± 0.92 | 50 ± 0.77 | / | / | 2.8 ± 0.06 | 3.125 ± 0.54 |
| 18 | Staphylococcus equorum | 1.3 ± 0.38 | 25 ± 0.86 | / | / | / | / | 0.9 ± 0.09 | 50 ± 0.89 |
| 19 | Listeria innocua | 1.2 ± 0.13 | 50 ± 0.02 | / | / | / | / | 1.0 ± 0.15 | 50 ± 0.32 |
| 20 | Weissella paramesenteroides | 2.0 ± 0.10 | 12.5 ± 0.08 | / | / | / | / | 1.0 ± 0.78 | 50 ± 0.21 |
| 21 | Weissella minor | 1.6 ± 0.06 | 6.25 ± 0.91 | / | / | / | / | 1.5 ± 0.92 | 6.25 ± 0.61 |
| 22 | Listeria monocytogenes | 1.5 ± 0.17 | 25 ± 0.07 | / | / | / | / | 1.6 ± 0.55 | 12.5 ± 0.45 |
| 23 | Lysinibacillus fusiformis | 3.1 ± 0.09 | 3.125 ± 0.65 | 2.8 ± 0.87 | 50 ± 0.34 | 2.3 ± 0.08 | 6.25 ± 0.66 | / | / |
| 24 | Bacillus subtilis | 3.2 ± 0.11 | 3.125 ± 0.15 | 1.7 ± 0.90 | 50 ± 0.08 | 1.7 ± 0.32 | 12.5 ± 0.08 | / | / |
| 25 | Planococcus psychrotoleratus | 1.3 ± 0.55 | 3.125 ± 0.03 | / | / | 2.1 ± 0.97 | 12.5 ± 0.70 | / | / |
| 26 | Bacillus amyloliquefaciens | 3.8 ± 0.72 | 3.125 ± 0.42 | / | / | 3.0 ± 0.77 | 12.5 ± 0.22 | / | / |
| 27 | Bacillus anthracis | 1.5 ± 0.04 | 12.5 ± 0.90 | / | / | 1.5 ± 0.58 | 25 ± 0.77 | / | / |
| 28 | Bacillus amyloliquefaciens | 1.5 ± 0.18 | 50 ± 0.65 | / | / | / | / | / | / |
| 29 | Bacillus cereus Bc1 | 2.0 ± 0.78 | 12.5 ± 0.43 | / | / | 1.2 ± 0.72 | 50 ± 0.09 | / | / |
| 30 | Bacillus cereus Bc2 | 2.6 ± 0.44 | 3.125 ± 0.75 | 2.4 ± 0.88 | 50 ± 0.77 | 2.7 ± 0.98 | 6.25 ± 0.54 | / | / |
| Gram-negative bacteria | |||||||||
| 31 | Pseudomonas fragi | 2.0 ± 0.43 | 50 ± 0.28 | 1.3 ± 0.77 | 50 ± 0.95 | / | / | 1.9 ± 0.98 | 50 ± 0.09 |
| 32 | Hafnia alvei | / | / | / | / | / | / | 1.3 ± 0.44 | 50 ± 0.88 |
| 33 | Pseudomonas proteamaculans | 1.4 ± 0.76 | 25 ± 0.98 | / | / | / | / | 1.6 ± 0.90 | 50 ± 0.67 |
| 34 | Escherichia coli | 2.0 ± 0.90 | 50 ± 0.75 | / | / | / | / | 2.5 ± 0.70 | 50 ± 0.07 |
| 35 | Salmonella serovar | 1.5 ± 0.35 | 50 ± 0.91 | 1.1 ± 0.34 | 50 ± 0.36 | / | / | 1.0 ± 0.39 | 50 ± 0.77 |
| 36 | Pseudomonas orientalis | 3.3 ± 0.22 | 3.125 ± 0.23 | 1.0 ± 0.58 | 50 ± 0.87 | 3.2 ± 0.40 | 6.25 ± 0.38 | / | / |
Publisher’s Note: MDPI stays neutral with regard to jurisdictional claims in published maps and institutional affiliations. |
© 2021 by the authors. Licensee MDPI, Basel, Switzerland. This article is an open access article distributed under the terms and conditions of the Creative Commons Attribution (CC BY) license (https://creativecommons.org/licenses/by/4.0/).
Share and Cite
Bonomo, M.G.; Giura, T.; Salzano, G.; Longo, P.; Mariconda, A.; Catalano, A.; Iacopetta, D.; Ceramella, J.; Sinicropi, M.S.; Saturnino, C. Bis-Thiourea Quaternary Ammonium Salts as Potential Agents against Bacterial Strains from Food and Environmental Matrices. Antibiotics 2021, 10, 1466. https://doi.org/10.3390/antibiotics10121466
Bonomo MG, Giura T, Salzano G, Longo P, Mariconda A, Catalano A, Iacopetta D, Ceramella J, Sinicropi MS, Saturnino C. Bis-Thiourea Quaternary Ammonium Salts as Potential Agents against Bacterial Strains from Food and Environmental Matrices. Antibiotics. 2021; 10(12):1466. https://doi.org/10.3390/antibiotics10121466
Chicago/Turabian StyleBonomo, Maria Grazia, Teresa Giura, Giovanni Salzano, Pasquale Longo, Annaluisa Mariconda, Alessia Catalano, Domenico Iacopetta, Jessica Ceramella, Maria Stefania Sinicropi, and Carmela Saturnino. 2021. "Bis-Thiourea Quaternary Ammonium Salts as Potential Agents against Bacterial Strains from Food and Environmental Matrices" Antibiotics 10, no. 12: 1466. https://doi.org/10.3390/antibiotics10121466
APA StyleBonomo, M. G., Giura, T., Salzano, G., Longo, P., Mariconda, A., Catalano, A., Iacopetta, D., Ceramella, J., Sinicropi, M. S., & Saturnino, C. (2021). Bis-Thiourea Quaternary Ammonium Salts as Potential Agents against Bacterial Strains from Food and Environmental Matrices. Antibiotics, 10(12), 1466. https://doi.org/10.3390/antibiotics10121466





